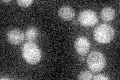
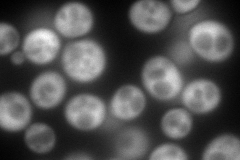
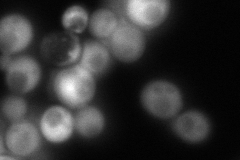
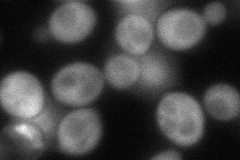

View description
DNA damage-responsive protein, expression is increased in response to heat-shock stress or treatments that produce DNA lesions; contains multiple repeats of the amino acid sequence NNNDSYGS
Localization:
Intensity:
Fold change:
Significance:
-
C’ GFP library in SD
below threshold18.46 -
N' NOP1pr-GFP in SD
cytosol389.445 -
N' TEF2pr-mCherry in SD

cytosol562.113 -
N' NATIVEpr-GFP in SD
cytosol124.221 -
N' TEF2pr-VC and Cyto-VN in SD
cytosol91.7691 -
C’ GFP library in SD+DTT

cytosol15.840.85No -
C’ GFP library in SD+H2O2

cytosol17.630.95No -
C’ GFP library in Starvation Media

cytosol13.030.7No -
C’ GFP library on the background of Pup2-DaMP

below threshold -
C’ GFP library on the background of CCT mutant

below threshold18.3740.995009No
